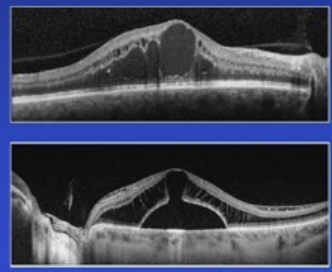
1761037656845382.png 1761037656845382.png
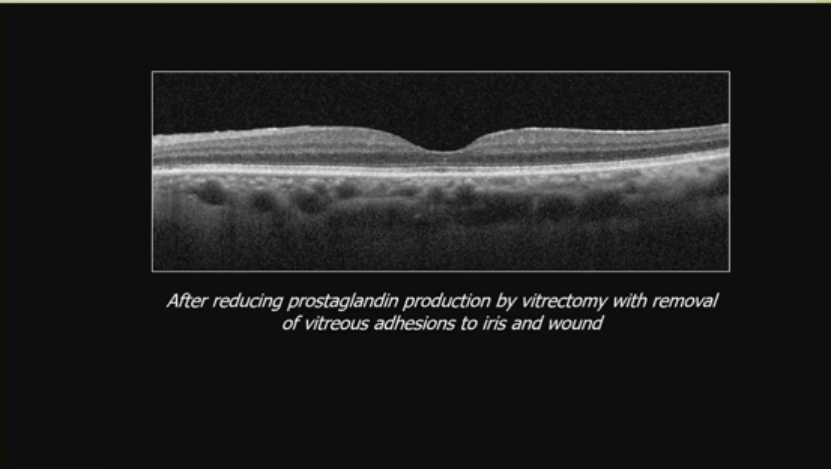
1761037715984862.png 1761037715984862.png
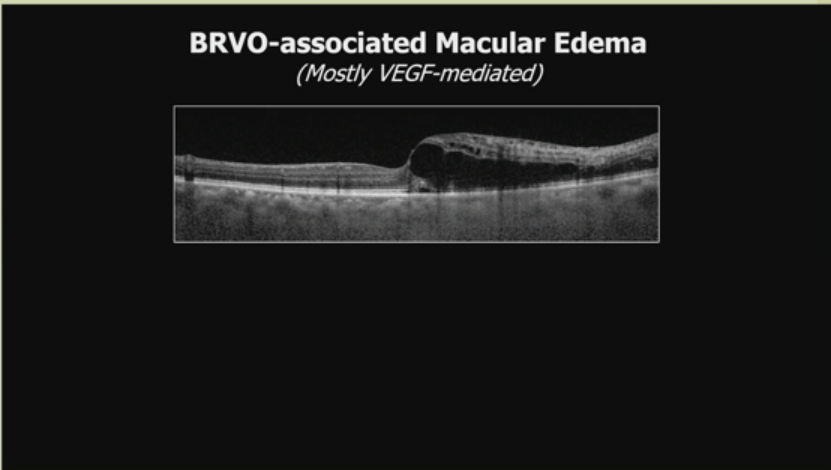
1761037758273392.png 1761037758273392.png

编者按:
今年的AAO大会中,来自University of Michigan Kellogg Eye Center的Mark W. Johnson教授分享了黄斑水肿的最新进展。从“影像识别”到“机制导向”,从“统一用药”到“个体化管理”,Johnson教授的报告为临床医生提供了一种更理性、更精准、更具层次的治疗思维框架。

发病机制:炎症与血管因子双重驱动

理解黄斑水肿的发生,需要从基本机制入手。主要机制包括:
· 血管通透性增加:这是“内血视网膜屏障”功能障碍的表现,可能伴随视网膜血流增加。
· RPE屏障或泵功能障碍:涉及“外血视网膜屏障”的问题。
· 牵拉应力:包括前后向玻璃体视网膜牵拉或视网膜前膜。
· 药物反应。
·渗透梯度:涉及退行性机制,如神经节细胞、穆勒胶质细胞或RPE的退化。
· 来自视盘的液体迁移。
这些机制往往通过光学相干断层扫描(OCT)图像显现,例如OCT显示的黄斑区液体积聚或屏障破坏。

这些OCT图像突出了机制的多样性,提醒医生在诊断时需仔细辨别。
合理且有效治疗的原则
Mark W. Johnson教授强调理性治疗原则,这些原则指导临床决策:
· 识别特定机制:通过彻底病史和检查,谨慎使用影像技术,如OCT,来明确病因。
· 针对特定因素定制治疗:运用多种工具,包括药物、激光和手术。避免过度依赖anti-VEGF剂。
· 从最简单、最少侵入性开始:例如,先尝试非手术方法。
· 如果无视力获益,停止治疗:避免不必要的成本和风险。
· 治疗患者,而非OCT图像:即关注临床症状,而非仅影像学变化。
临床案例
Mark W. Johnson教授通过一系列临床案例说明治疗原则,展示如何应用上述机制和原则。
炎症性疾病-术后囊样黄斑水肿(CME):

一个复杂白内障手术后的CME案例,对药物治疗无响应。图像显示荧光血管造影和OCT上的水肿。治疗通过玻璃体切割术减少前列腺素产生,移除玻璃体对虹膜和伤口的粘连,后OCT显示水肿消退2.BRVO相关黄斑水肿(主要VEGF介导):

OCT显示典型水肿。案例中,一患者接受超过50次贝伐珠单抗注射,主观获益最小。单次局灶激光光凝后9个月,视力恢复至20/25,患者高兴停止注射。另一案例显示每6周复发CME的患者,经周边散射激光后2年无复发,无需更多贝伐珠单抗。
3.1型黄斑毛细血管扩张(Coats病,通常非VEGF介导):

荧光血管造影和OCT显示异常。局灶激光后3个月,OCT显示水肿改善。
4.大动脉瘤相关黄斑水肿(不太可能VEGF介导):

荧光血管造影和OCT显示水肿。局灶激光后8个月,视力20/30。
5.糖尿病黄斑水肿:





anti-VEGF是主力,但优化代谢和心血管状态有益。案例显示系统控制后视网膜改善。另一渐进性威胁黄斑中心的DME,尽管多次贝伐珠单抗,仍需局灶激光,1年后改善。Protocol V案例:41岁1型糖尿病患者,轻度中心涉及DME,选择观察,6年和9年后视力仍20/25。另一65岁单眼糖尿病患者,水肿因糖尿病血管病、肾功能下降和既有ERM,贝伐珠单抗x2后ERM剥离视力20/25,透析后进一步改善至20/50。
6.脉络膜血管疾病相关黄斑水肿:


56岁男性水肿对每月贝伐珠单抗无响应2年。影像确认慢性中心性浆液性脉络膜视网膜病变后,转光动力疗法(PDT)。
7.药物反应相关黄斑水肿:


芬戈莫德诱导CME(礼遇Neal Jan医生)。另一白内障术后2年,使用比马前列素6个月的OCT显示水肿,停药并用酮咯酸QID 6周后改善。
8. 牵拉性黄斑水肿:

OCT显示牵拉。玻璃体黄斑牵拉案例,患者曾接受subTenon曲安奈德x4并推荐玻璃体内激素,但需评估多药失败。高度近视牵拉黄斑病变,通过PPV剥离后玻璃体、视网膜前膜和内界膜,术后改善。
9. 视网膜营养不良相关“水肿”:





图像显示相关变化。X连锁视网膜劈裂症:45岁男性“顽固水肿”,基因确认XLRS后,用多佐拉胺,6个月后改善。
10. 退行性黄斑囊肿/腔隙:

覆盖地理萎缩的AMD。
11. 肿瘤性黄斑水肿:

免疫球蛋白病黄斑病变,FA“无声”。
12. 来自视盘的液体迁移相关黄斑水肿:



腔隙视盘异常或视盘毛细血管渗漏。视盘坑黄斑病变:5秒OCT显示20/200,FLP、PPV、Fox后20/30。视盘渗漏:神经视网膜炎(巴尔通体、病毒后、梅毒)、糖尿病视盘病、高血压视盘病、炎症浸润(结节病),治疗底层疾病。
这些案例突显个性化治疗的重要性,避免过度使用单一方法。
小结
Johnson教授的系列病例提醒我们——在抗VEGF成为主流的时代,更应警惕“过度依赖”的陷阱。只有回归病理机制本身,识别炎症、血管、牵拉、代谢等多重驱动因素,才能制定出真正安全、有效且可持续的治疗方案。
未来,黄斑水肿的管理将不再以药物类别为中心,而是以病理机制为核心、以患者整体为导向的综合策略,为视功能恢复与生活质量提升开辟新的方向。
声明:本文仅供医疗卫生专业人士学术交流,不代表本平台观点。该等信息不能以任何方式取代专业的医疗指导,也不应被视为诊疗建议,如果该信息被用于资讯以外的目的,本平台及作者不承担相关责任。